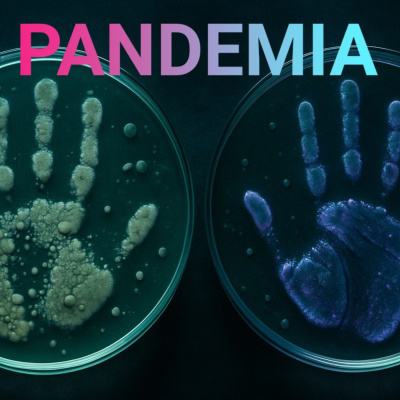
Serien

Serien
Gefährliche Forschung (2) | Synthetische Zellen und die Pandemie aus dem Spiegel
- Author: Vários
- Narrator: Vários
- Publisher: Podcast
- Duration: 1:04:37
- More information
Informações:
Synopsis
Im Labor Bakterien erschaffen, die spiegelverkehrt zum Leben auf der Erde sind? Wie faszinierend, denkt sich die Forscherin Kate Adamala und beginnt die Grundlagenforschung dazu. Was aber wenn so ein Mikroorganismus, zu einer Pandemie führen könnte, wie es sie noch nie gab; der Menschen, Tiere und Pflanzen hilflos gegenüberstehen, denkt der Wissenschaftler Kevin Esvelt. Das Pandemia-Team spricht mit den beiden darüber, wie sie schließlich zum gleichen Schluss gekommen sind und was die Menschheit jetzt tun kann, um die Erschaffung von Spiegelleben zu verhindern.